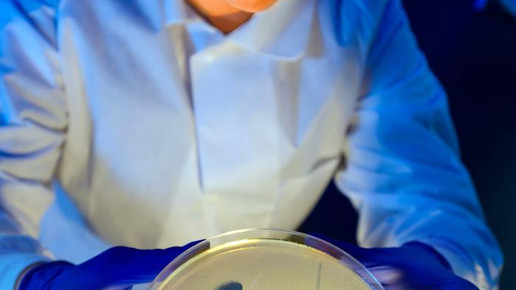

Kein Antibiotikum wirksam: Frau stirbt
In den USA ist eine Klinikpatientin an einer Infektion mit einem „panresistenten“ Keim gestorben. Keines der 26 zugelassenen Antibiotika habe Wirkung gegen den Erreger vom Typ Klebsiella pneumoniae gezeigt, teilte das US-Seuchenabwehrzentrum CDC mit.
Die Rentnerin sei in den vergangenen Jahren länger in Indien gewesen und dort wegen eines Bruchs ihres rechten Oberschenkels behandelt worden. In den vergangenen zwei Jahren hatte sie mehrere Krankenhausaufenthalte, unter anderem wegen Osteomyelitis.
Im August wurde sie in ein Krankenhaus in Reno im US-Bundesstaat Nevada eingeliefert, wo sie im September auf der Isolierstation starb. Alle 26 in den USA zugelassenen Antibiotika hätten bei der über 70-jährigen Frau nicht geholfen.
Multiresistente Bakterien machen Medizinern zunehmend Sorge, weil sie Infektionen unheilbar werden lassen. Es ist zwar nicht das erste Mal, das die Schulmedizin bei einer Infektion komplett versagt, dennoch sind die Seuchenexperten in den USA alarmiert. CDC-Direktor Dr. Tom Frieden nannte Carbapenem-resistente Enterobakterien einen „Albtraum“.
Erst Anfang Januar war im Krankenhaus Bad Cannstatt ein mit einem hochresistenten Keim besiedelter Patient gestorben – allerdings nicht wegen des Erregers. „Die Todesursache steht eindeutig nicht in Zusammenhang mit dem Keim“, betonte das Klinikum Stuttgart aus dem Krankenhausverbund, ohne weitere Details zu nennen. Zuvor war bekanntgeworden, dass bei fünf Patienten in Bad Cannstatt das Bakterium Acinetobacter baumannii nachgewiesen wurde. Alle waren laut Krankenhaus mit dem Keim nur besiedelt, Symptome einer Infektion zeigten sie nicht.
Vier der fünf Patienten trugen eine hochresistente Variante des Erregers, gegen die fast alle Antibiotika nicht mehr wirken. Der fünfte mit A. baumannii besiedelte Patient hatte einen Typ mit schwächerer Resistenz, der noch auf mehrere Antibiotika anspricht. Er wurde den Angaben zufolge von der Intensivstation in ein isoliertes Zimmer einer Normalstation verlegt.
Anfang Dezember war der Erreger den Angaben zufolge bei einem Patienten bei der Aufnahme zur Intensivbehandlung festgestellt worden. Danach wurde er in einem isolierten Bereich behandelt und gepflegt. Bei einer routinemäßigen Überprüfung wurde der Keim demnach bei vier weiteren Patienten festgestellt. Für Gesunde ist A. baumannii im Regelfall ungefährlich. Bei geschwächten Menschen können die Bakterien aber unter anderem Lungenentzündungen, Wundinfektionen und Blutvergiftungen verursachen.

APOTHEKE ADHOC Debatte